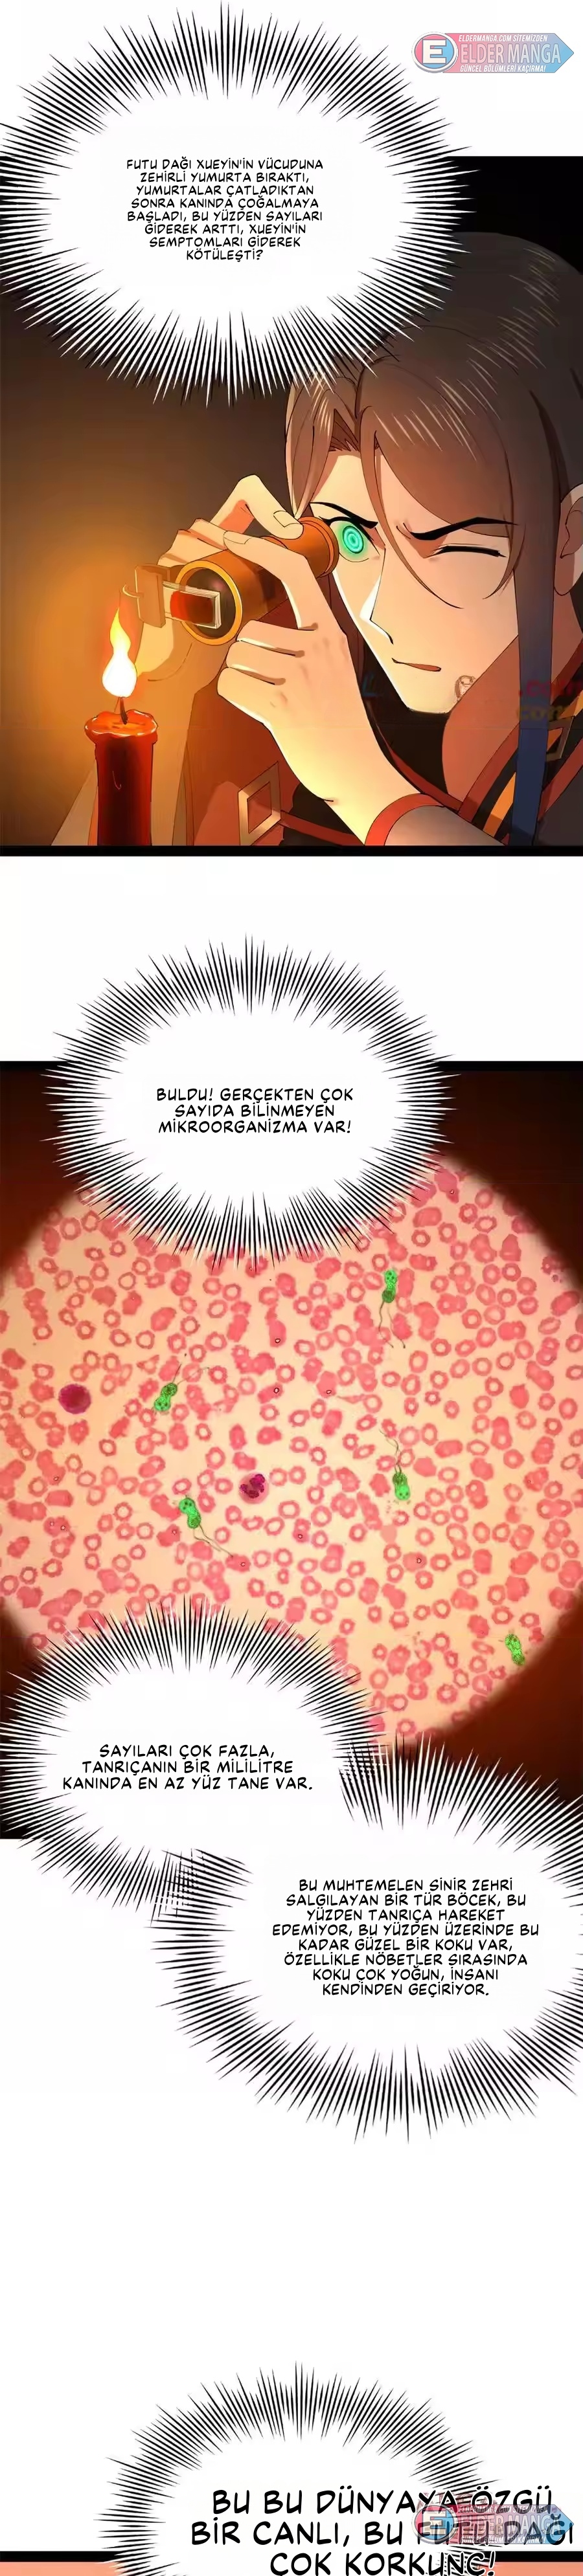
Dünyanın En Güçlü Eniştesi Bölüm 219 - Sayfa 10

Bölüm Sorunu Bildir
Bölüm Seç

Dünyanın En Güçlü Eniştesi 219 Oku
Dünyanın En Güçlü Eniştesi mangasının 219'u Turkce olarak Webtoonoku | Türkçe Manga, Manhwa, Manhua ve Webtoon Oku uzerinde yayinlanmistir. Bu serisi severek takip eden okuyucular, her gun yeni bolumleri hizli bir sekilde platformumuzda bulabilmektedir. Aksiyon, DOĞAÜSTÜ, Dövüş Sanatları, Drama, FANTASTİK, Komedi, MACERA, Manhua, Romantik, Romantizm, SHOUNEN, Yapay Zeka Çeviri kategorisinde yer alan bu eser, Aksiyon, DOĞAÜSTÜ, Dövüş Sanatları, Drama, FANTASTİK, Komedi, MACERA, Manhua, Romantik, Romantizm, SHOUNEN, Yapay Zeka Çeviri ve daha bircok turde icerikle zengin kutuphanemizin parcasidir.
Webtoonoku | Türkçe Manga, Manhwa, Manhua ve Webtoon Oku ile Turkce manga oku, webtoon oku, manhwa oku ve webtoon oku org aramalarinda one cikan bolumlere kolayca ulasabilirsiniz.
Neden Dünyanın En Güçlü Eniştesi Okumalısınız?
- Türkçe Çeviri: Tüm bölümler profesyonel çevirmenler tarafından Türkçeye çevrilmiştir.
- Güncel Güncellemeler: Yeni bölümler en hızlı şekilde eklenmektedir.
- Reklamsız Okuma: İstenmeyen reklamlardan rahatsız olmadan rahat oku.
- Kolay Erişim: Tüm cihazlarda sorunsuz okuma deneyimi.
Dünyanın En Güçlü Eniştesi Kategoriler
Bu seri Aksiyon, DOĞAÜSTÜ, Dövüş Sanatları, Drama, FANTASTİK, Komedi, MACERA, Manhua, Romantik, Romantizm, SHOUNEN, Yapay Zeka Çeviri kategorilerinde sınıflandırılmıştır. Benzer içerikleri keşfetmek için bu kategorileri ziyaret edebilirsiniz.
Sıkça Sorulan Sorular
📚 Dünyanın En Güçlü Eniştesi Hakkında Bilgi
Dünyanın En Güçlü Eniştesi serisi, Devam Ediyor durumunda olan ve Aksiyon, DOĞAÜSTÜ, Dövüş Sanatları, Drama, FANTASTİK, Komedi, MACERA, Manhua, Romantik, Romantizm, SHOUNEN, Yapay Zeka Çeviri kategorilerinde yer alan bir eserdir. Okuyan okuyucular tarafından yüksek beğeni alan bu seri, benzersiz hikayesi ve çarpıcı karakterleriyle dikkat çekmektedir.
⚡ Yeni Bölümler Ne Zaman Eklenir?
Platformumuzda, Dünyanın En Güçlü Eniştesi gibi popüler seriler en hızlı şekilde güncellenmektedir. Bölümler orijinal kaynaktan yayınlandıktan kısa bir süre sonra Türkçe çevirisiyle birlikte eklenmektedir.
💝 Seriyi İzlemeleri Nasıl Yaparım?
Dünyanın En Güçlü Eniştesi serisini takip etmek için web sitesinde bulanan "Yer İşareti" özelliğini kullanabilirsiniz. Böylece tüm yeni bölümler eklendiğinde haber alabilir ve hızlı bir şekilde okumaya başlayabilirsiniz.
🌐 Dünyanın En Güçlü Eniştesi Türkçe Oku
Platformumuzda Dünyanın En Güçlü Eniştesi serisinin tüm bölümlerini Türkçe çevirisiyle okuyabilirsiniz. Yüksek kaliteli çeviri ekibimiz, her bölümü dikkatli bir şekilde çevirip düzenlemektedir.
✨ Benzer Seriler
Dünyanın En Güçlü Eniştesi gibi Aksiyon, DOĞAÜSTÜ, Dövüş Sanatları, Drama, FANTASTİK, Komedi, MACERA, Manhua, Romantik, Romantizm, SHOUNEN, Yapay Zeka Çeviri kategorisindeki diğer serileri keşfetmek istiyorsanız, kategori sayfamızı ziyaret edebilirsiniz. Benzer beğenileri paylaşan okuyucu topluluğumuz her gün yeni seriler keşfetmektedir.
💡 Okuma İpuçları
- Tam ekran modunu kullanarak daha iyi bir okuma deneyimi yaşayın
- Bölümü yer işaretine ekleyerek daha sonra kolayca bulabilirsiniz
- Diğer bölümleri keşfetmek için alt kısımdaki bölüm listesini kullanın
- Mobil cihazda okuyorsanız, düşük veri kullanımı modunu etkinleştirin
Topluluk
Dünyanın En Güçlü Eniştesi serisini baska okuyucularla tartismak istiyorsaniz, yorum bolumune fikirlerinizi yazabilirsiniz. Webtoonoku | Türkçe Manga, Manhwa, Manhua ve Webtoon Oku okuyucu toplulugu her gun serileri ve karakterleri tartismakta, teoriler uretmektedir.
Anahtar aramalar: Turkce manga oku, webtoon oku, webtoon oku org, manhwa oku.
Senin Tepkin Ne?
0 Tepki







Webtoonoku | Türkçe Manga, Manhwa, Manhua ve Webtoon Oku Yorum Kuralları